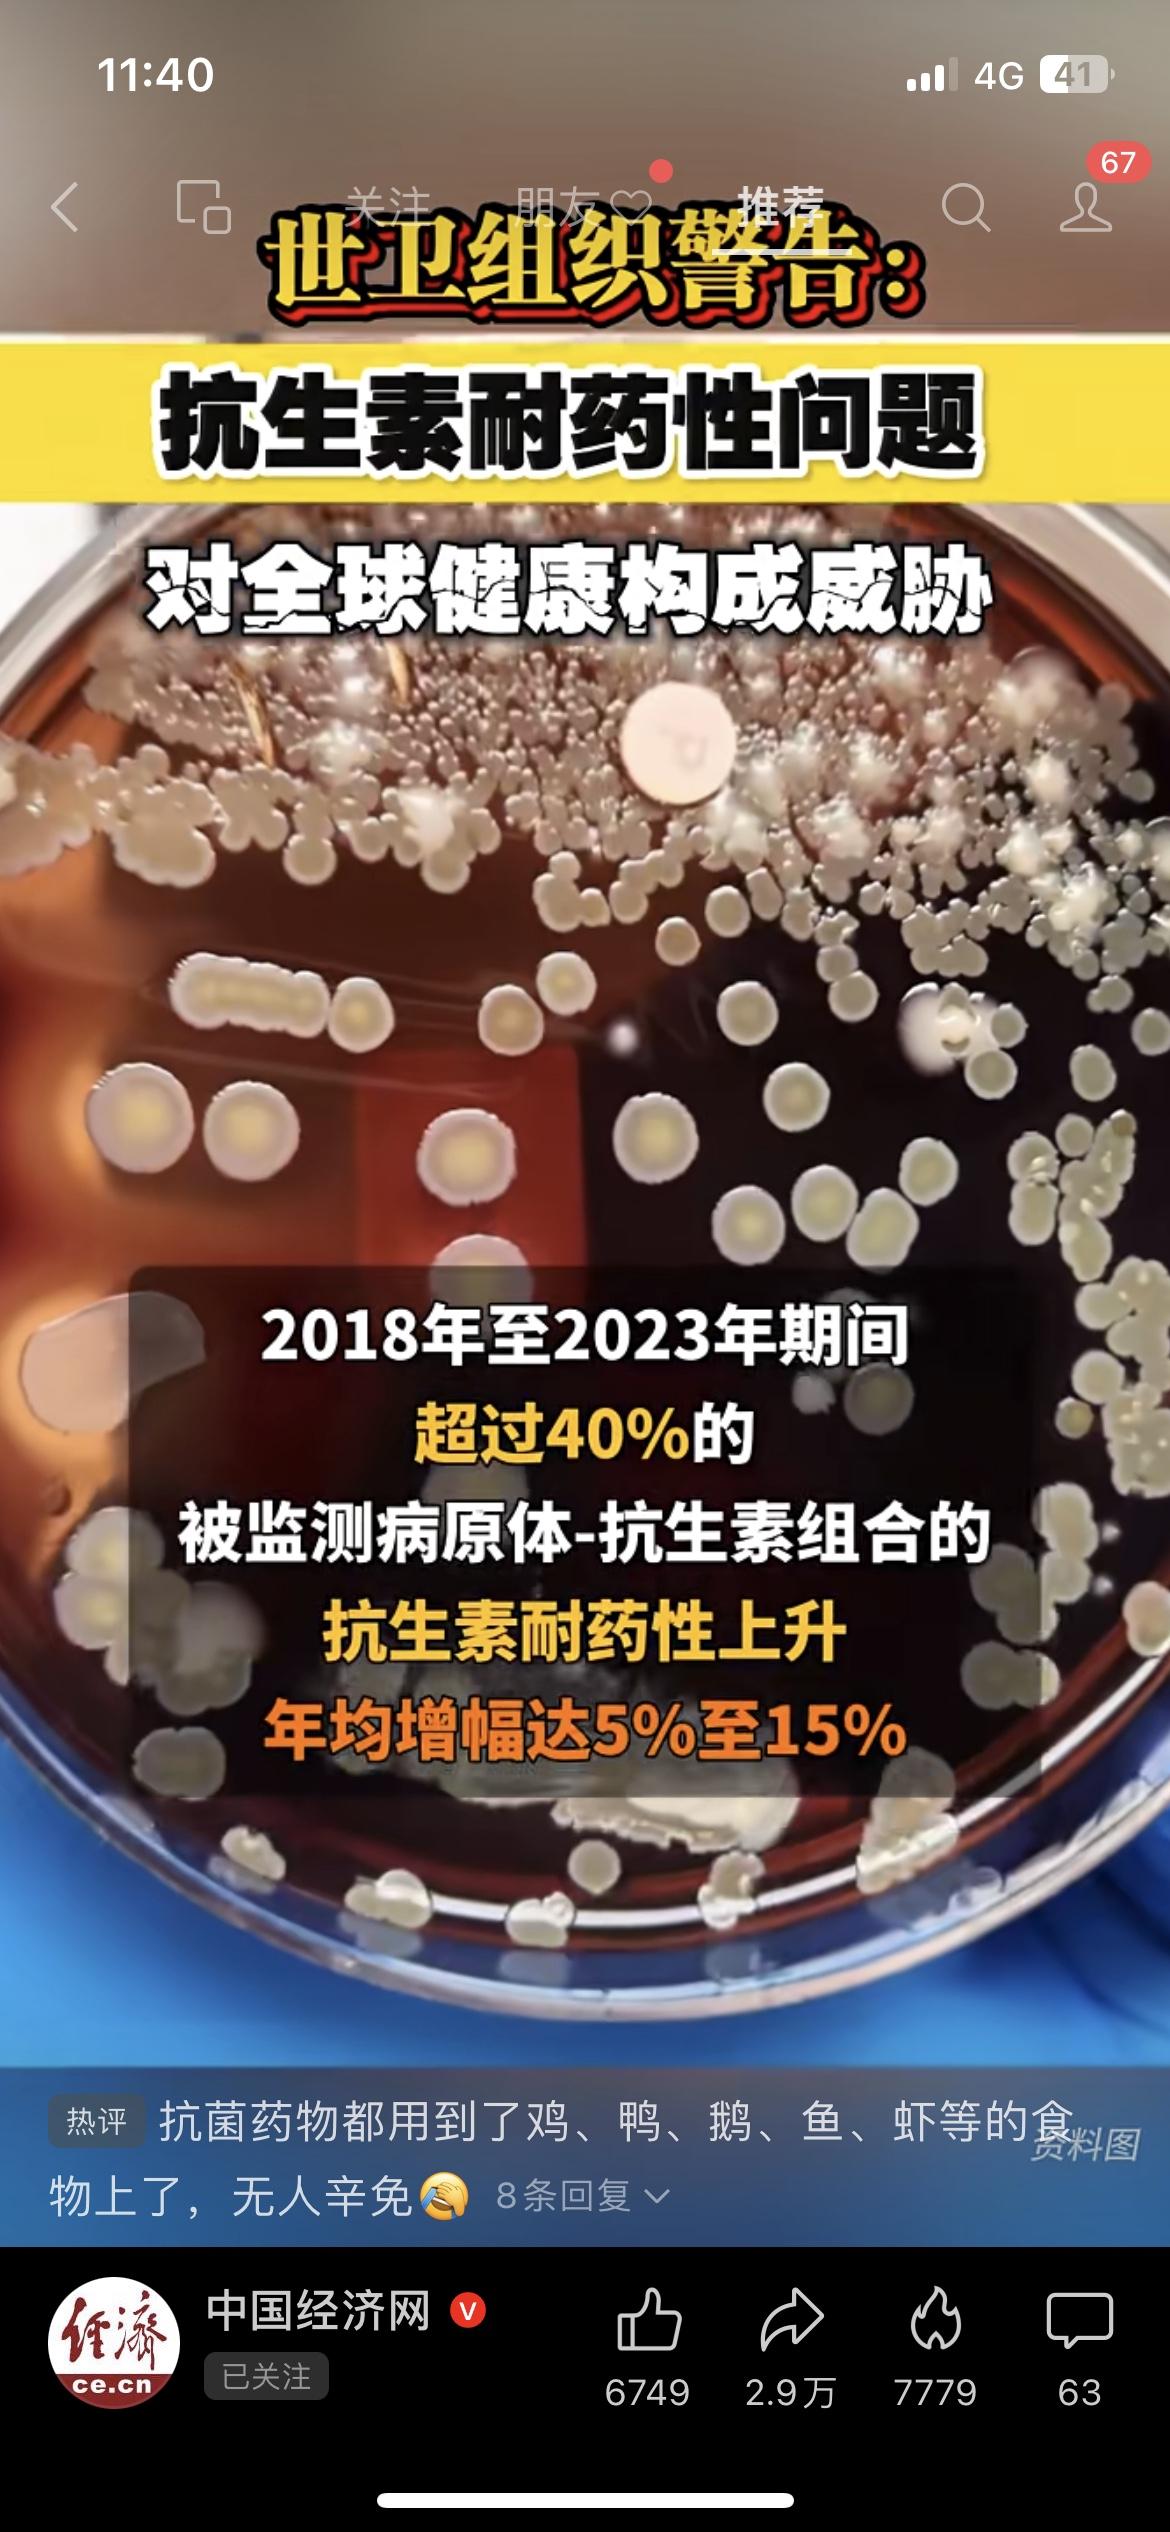
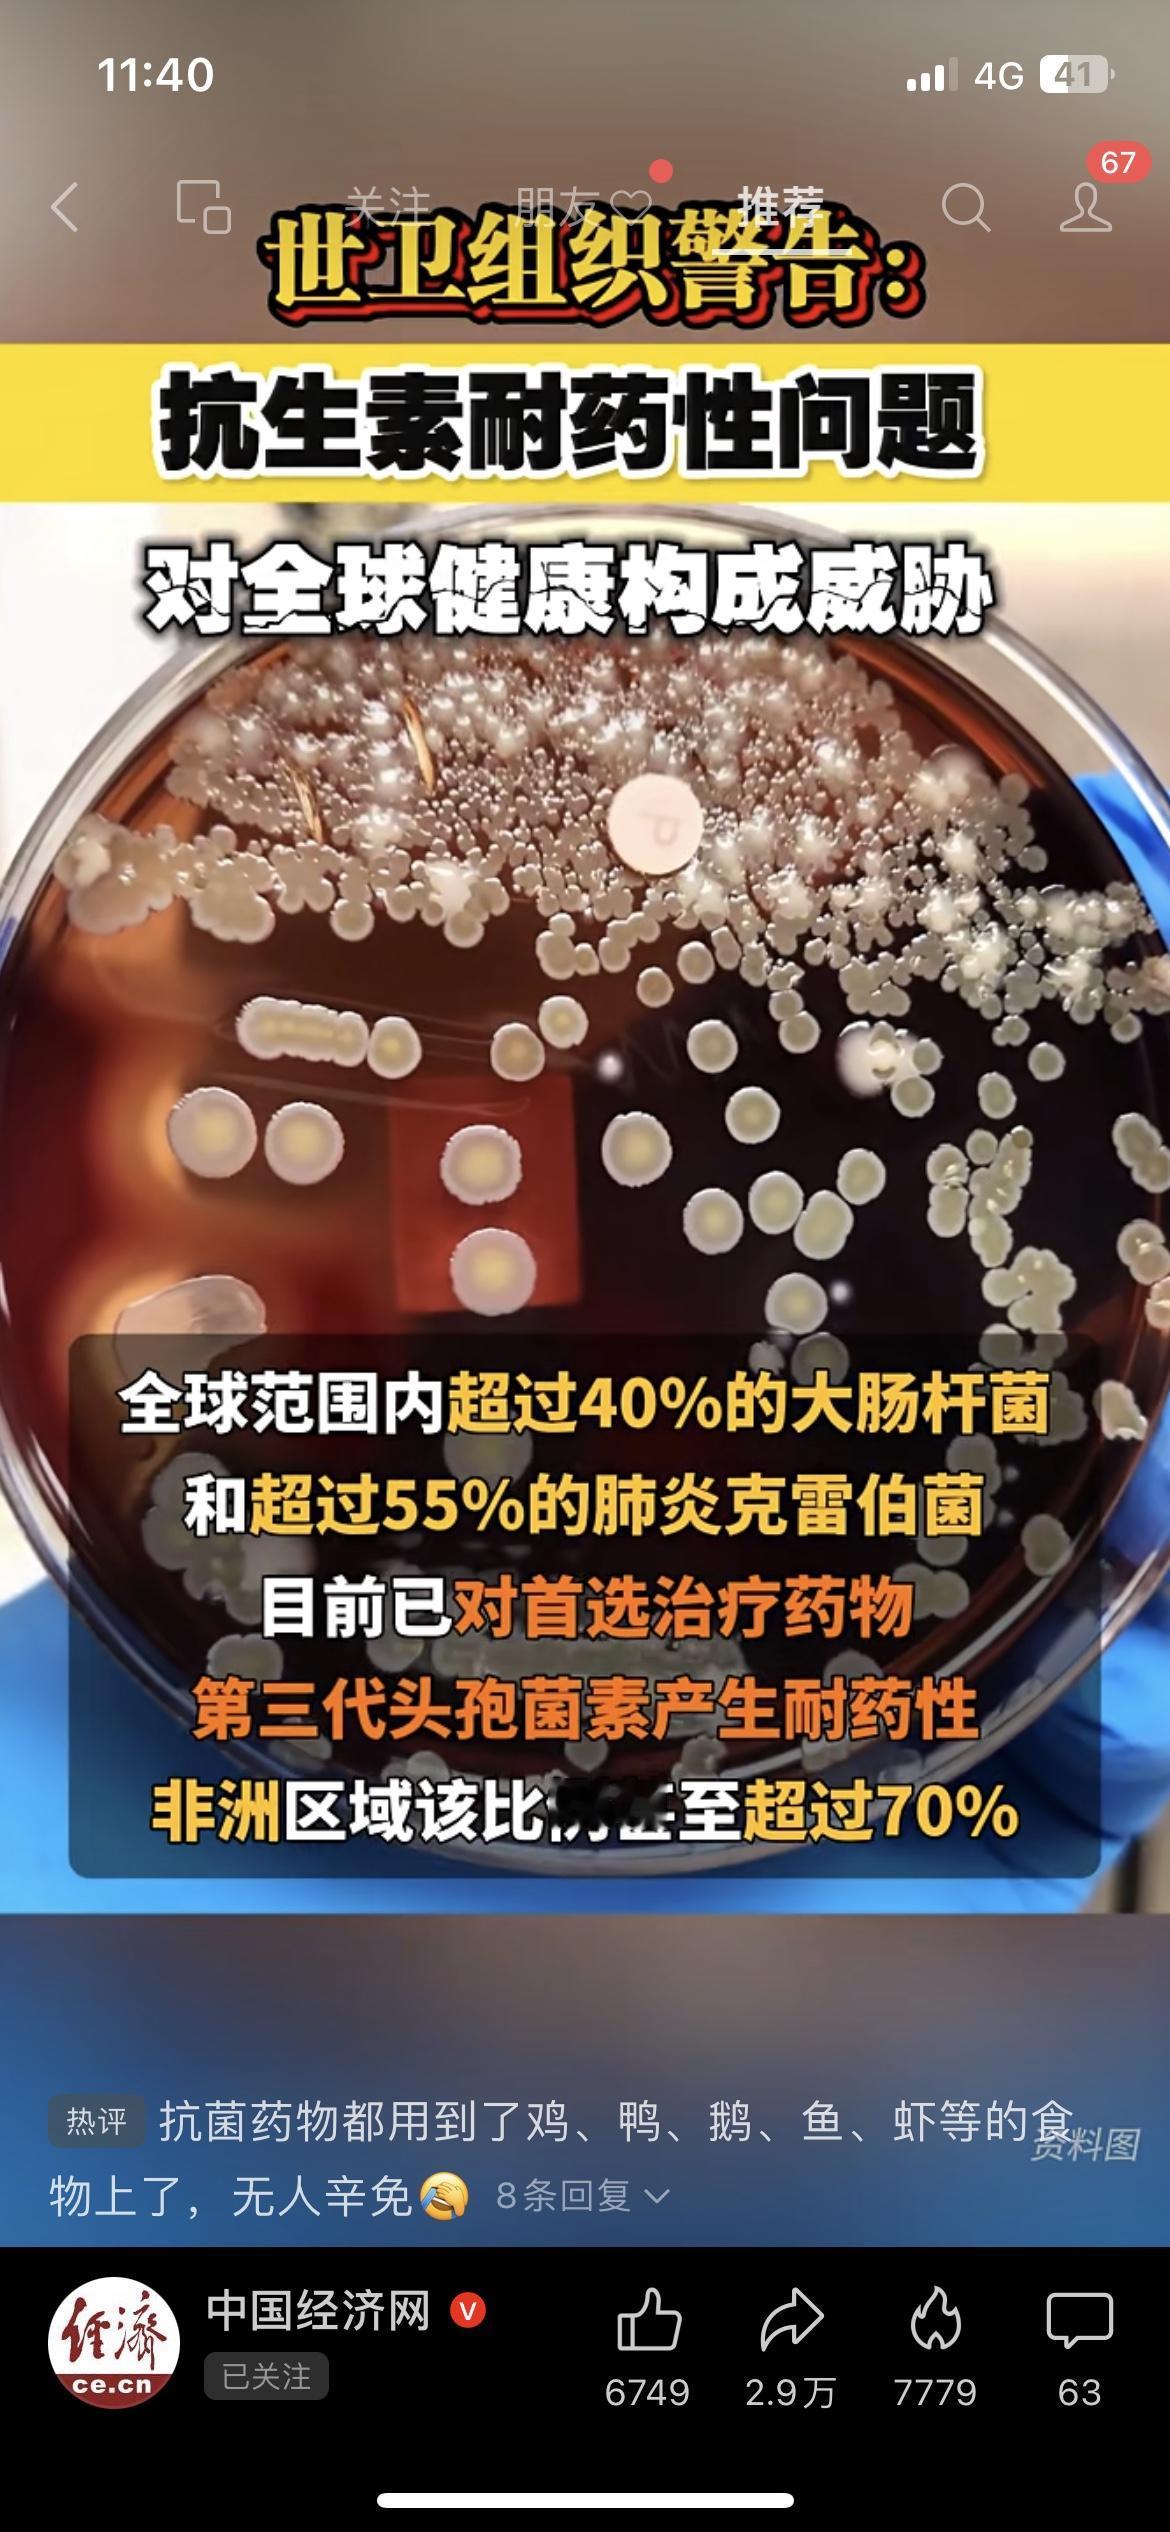
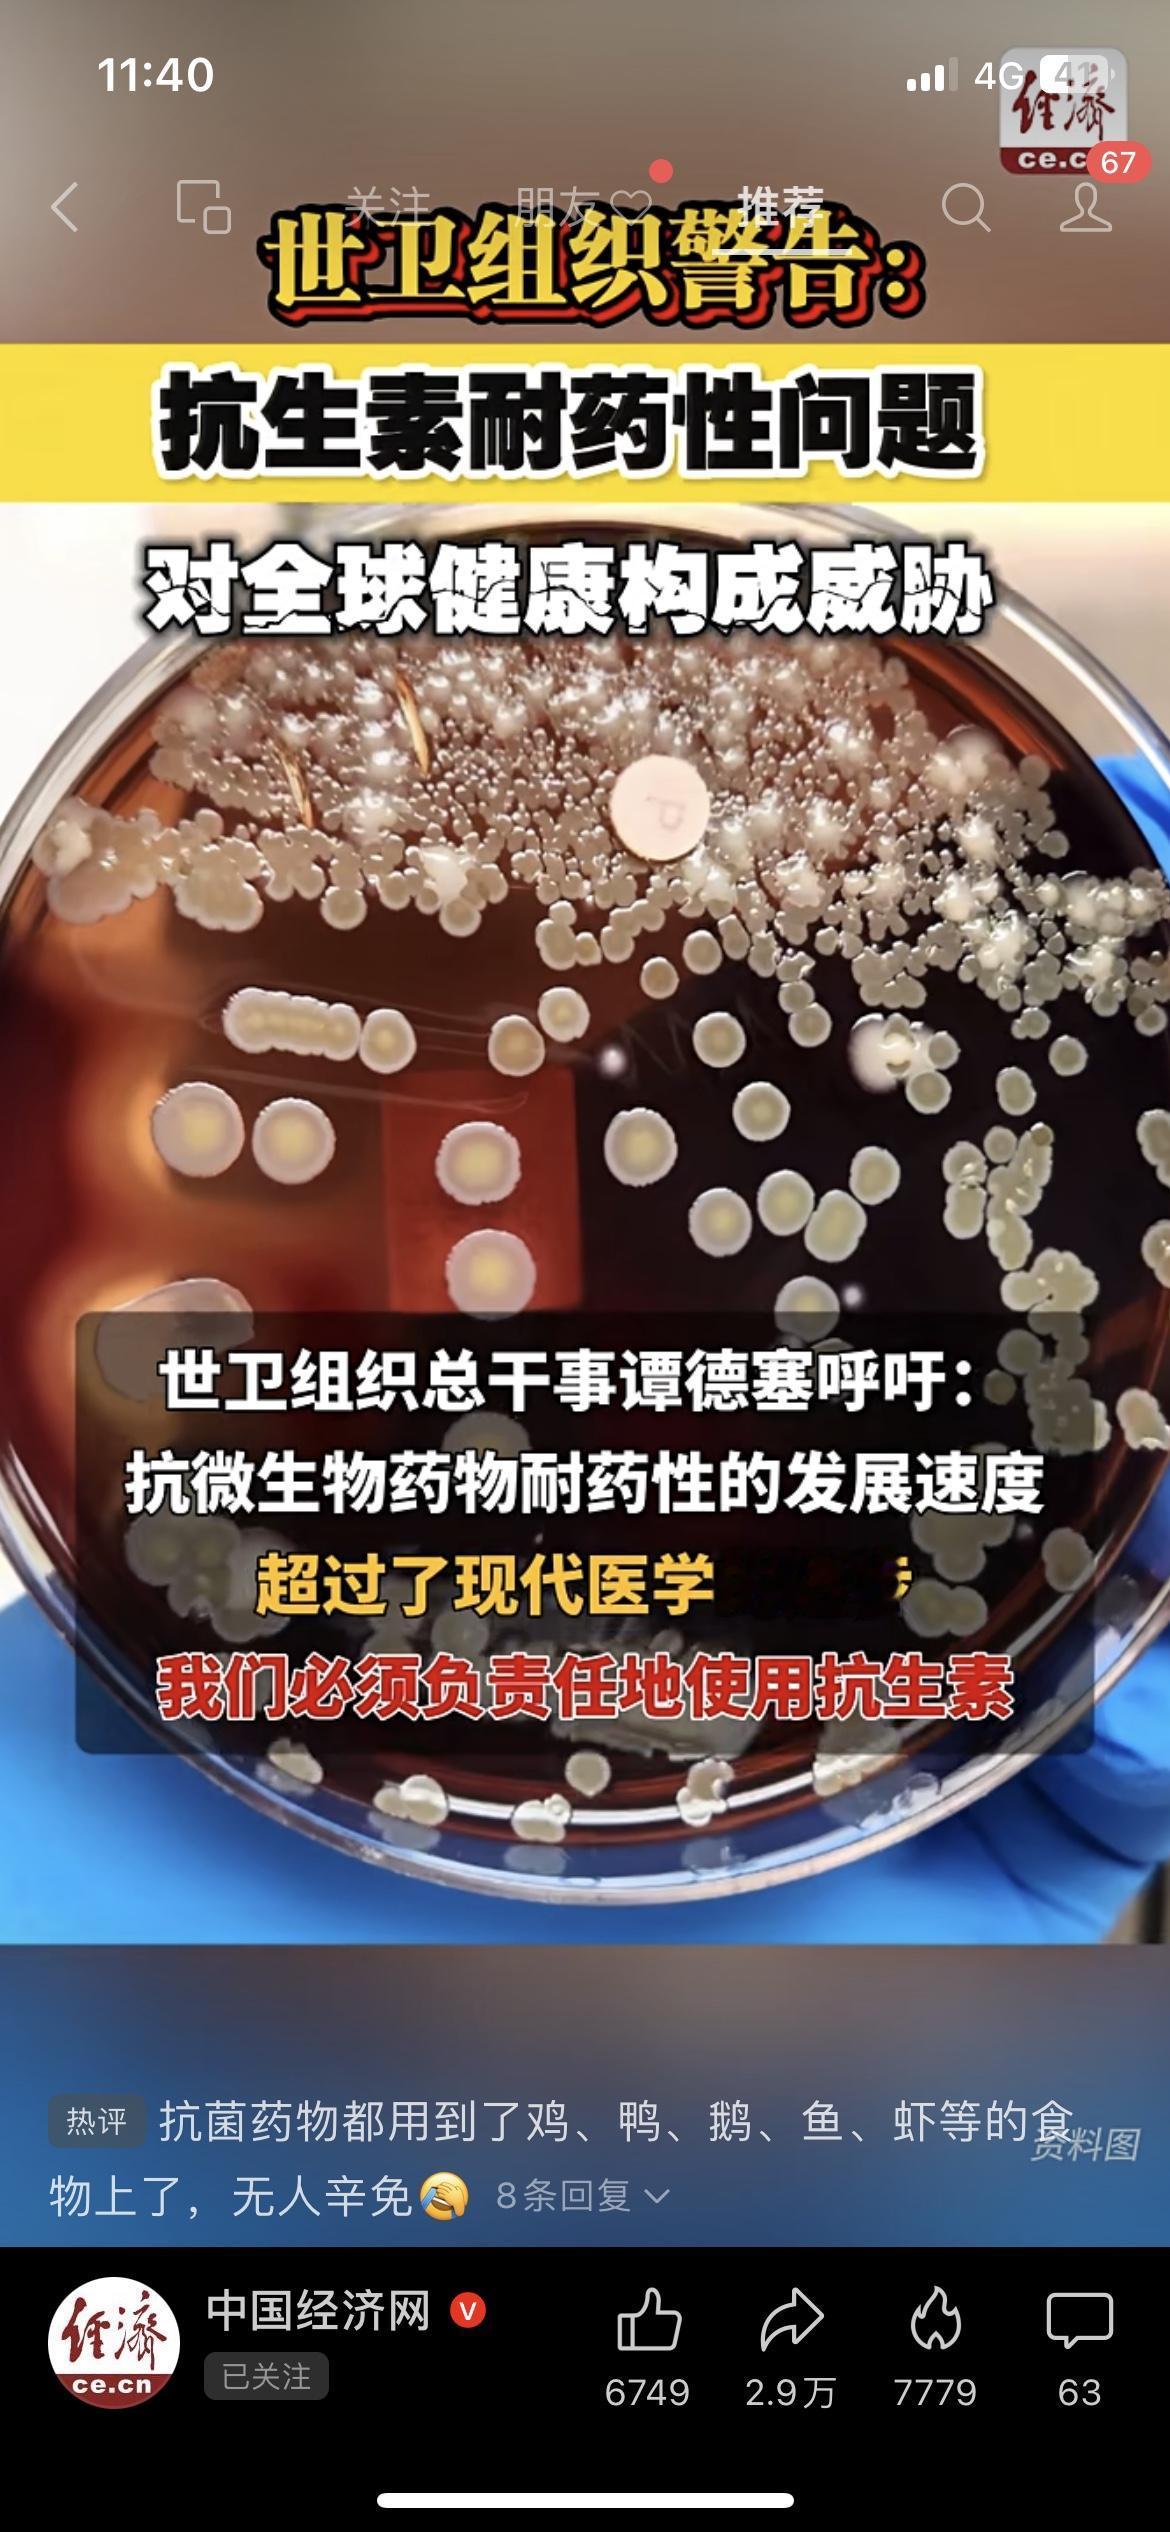

世卫紧急警告!抗生素耐药性全球大爆发,你的健康可能正被威胁 世卫组织重磅警告:抗生素耐药性问题已经对全球健康构成严重威胁!2018-2023年,超过40%的病原体-抗生素组合耐药性上升,年均涨幅5%-15%。全球超40%大肠杆菌、55%肺炎克雷伯菌对三代头孢耐药,非洲甚至超70%! 以后感冒发烧可能无药可治?世卫总干事呼吁必须负责任用抗生素。家人们,你们平时会乱买抗生素吃吗? 健康警示 抗生素耐药 全球健康





世卫紧急警告!抗生素耐药性全球大爆发,你的健康可能正被威胁 世卫组织重磅警告:抗生素耐药性问题已经对全球健康构成严重威胁!2018-2023年,超过40%的病原体-抗生素组合耐药性上升,年均涨幅5%-15%。全球超40%大肠杆菌、55%肺炎克雷伯菌对三代头孢耐药,非洲甚至超70%! 以后感冒发烧可能无药可治?世卫总干事呼吁必须负责任用抗生素。家人们,你们平时会乱买抗生素吃吗? 健康警示 抗生素耐药 全球健康